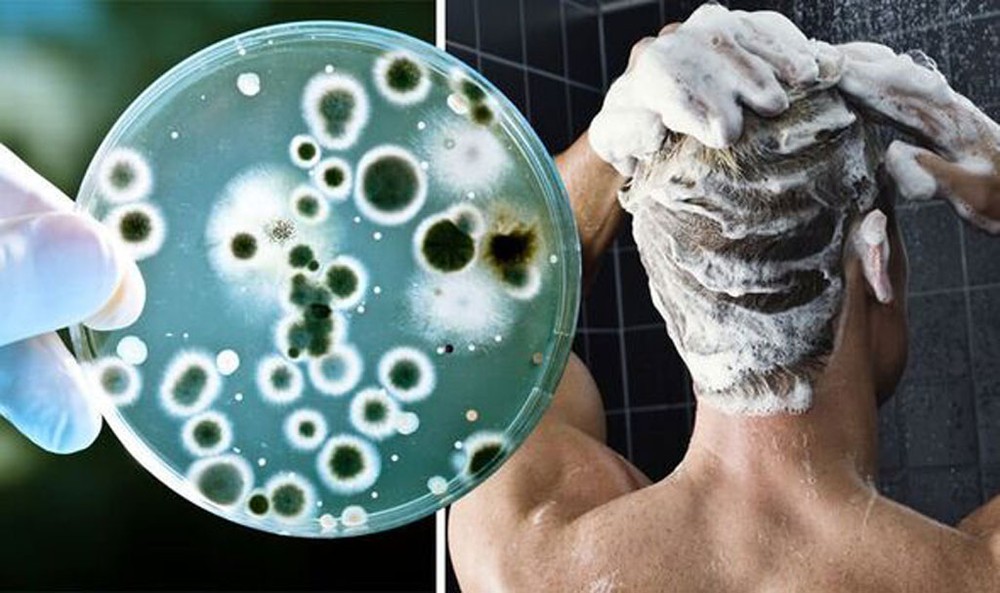

-
Dự báo điểm chuẩn tuyển sinh đại học năm 2026: Điểm chuẩn của nhiều trường đại học có thể giảm so với 2025? -
Phó Thủ tướng: Nghiên cứu sắp xếp 705 đơn vị hành chính cấp xã không đủ tiêu chuẩn trong năm 2026 -
Cả nước có 5 thủ khoa đạt điểm tuyệt đối 30/30 kỳ thi tốt nghiệp THPT 2026 -
Bất ngờ môn thi có nhiều điểm liệt nhất kỳ thi tốt nghiệp THPT 2026, vượt xa các môn còn lại -
Bảng xếp hạng điểm thi tốt nghiệp THPT: Hà Nội đứng thứ 2, tỉnh dẫn đầu và tỉnh ‘đội sổ’ gây chú ý -
Hà Nội áp dụng Vùng phát thải thấp: Xe máy, ô tô xăng bị hạn chế theo khu vực và khung giờ từ 1/7 -
Tin bão mới nhất: Áp thấp trên Biển Đông sắp thành bão số 1, miền Bắc chuẩn bị đón mưa dông kéo dài -
Nóng: Bộ Giáo dục chính thức công bố phổ điểm tất cả các môn thi tốt nghiệp THPT 2026 -
Tai nạn thương tâm: Nam sinh viên Đại học Luật tử vong sau va chạm với trâu thả rông -
Tranh cãi Mercedes-Benz vượt ẩu trên cao tốc Hà Nội – Hải Phòng và cái kết bị húc văng như bóng
Lối Sống
27/08/2023 22:03Bác sĩ cảnh báo: Không vệ sinh thứ này trong phòng tắm đúng cách có thể gây tổn thương da, phổi
Vòi tắm hoa sen gây tổn thương da, phổi nếu không được vệ sinh đúng cách
Chia sẻ trên tờ NY Post, BS Scott Walter (chuyên gia bệnh truyền nhiễm, đến từ Anh) tiết lộ, mọi người nên vệ sinh vòi hoa sen trong phòng tắm để tránh làm tổn thương da, phổi.
Trong video TikTok lan truyền với 5,5 triệu lượt xem, bác sĩ này chia sẻ, cảnh báo này do các chuyên gia hàng đầu cung cấp trong một hội nghị da liễu mới diễn ra. Cũng trong đoạn clip, BS Walter mô tả bên trong vòi hoa sen có cả tập đoàn vi khuẩn khổng lồ sinh sống. Thế nhưng hầu hết người dùng lại chủ quan, chưa thực sự biết cách diệt những vi khuẩn này.
Theo tạp chí Bệnh truyền nhiễm mới nổi, tập đoàn vi khuẩn ở khu vực này không thể được loại bỏ "bằng cách rửa nhẹ nhàng". Đặc biệt, chúng có thể gây ra các tình trạng về da, vấn đề về hô hấp. Đây là chuyện thường gặp ở những khu vực bị bỏ quên trong quá trình làm sạch như vòi tắm hoa sen.
Chuyên gia cảnh báo, những người bị suy giảm miễn dịch, như người hút thuốc thường xuyên hoặc những người mắc bệnh phổi, nên lưu ý đến việc tập đoàn vi khuẩn tồn tại ngay trong vòi hoa sen khi tắm.
"Khi bạn tắm, những vi khuẩn, nấm men và các loại nấm khác sẽ được khí dung hóa, chuyển thành dạng xịt mịn. Chúng có thể xâm nhập vào phổi, gây ảnh hưởng đến da và nhiều bộ phận khác trên cơ thể", chuyên gia cho hay.
BS Walter nhận định, những vi khuẩn này "có thể gây tổn thương da và các khu vực khác trên cơ thể như mắt, da đầu, tai, đường tiêu hóa, phổi...".
Trang Medline Plus (Viện Y tế Quốc gia Mỹ) cho biết thêm, trong vòi tắm hoa sen luôn có một loại vi khuẩn tên là mycobacteria. Đây là một sinh vật gây hại có liên quan đến một loại bệnh nhiễm trùng phổi, gọi là vi khuẩn mycobacteria.
Một nghiên cứu của Hiệp hội Vi sinh vật học Hoa Kỳ cũng tìm thấy vi khuẩn trong vòi hoa sen và hít phải vi khuẩn mycobacteria dạng khí dung khi tắm.
Làm sao để vệ sinh vòi tắm hoa sen đúng cách, ngăn chặn bệnh da, phổi?
BS Walter hướng dẫn mọi người nên làm sạch đầu vòi tắm hoa sen bằng giấm trắng theo 2 phương pháp. Một là nhúng đầu vòi tắm hoa sen vào bát giấm trắng, ngâm trong 4 giờ hoặc qua đêm. Hoặc, bạn bọc đầu vòi tắm hoa sen trong một túi nhựa chứa đầy giấm trắng và buộc dây cao su quanh ống vòi hoa sen.
Chuyên gia đặc biệt nhấn mạnh, đầu vòi hoa sen nên được làm sạch ít nhất mỗi tháng một lần, điều mà người bình thường không làm bao giờ. Hoặc chúng ta chỉ dội rửa qua loa, không đủ vệ sinh đúng nghĩa.
Ngoài vòi tắm hoa sen, trong phòng tắm còn có những đồ dùng khác cũng là ổ chứa vi khuẩn
1. Rèm tắm, sàn tắm
Nhiều nhà nghiên cứu đã kiểm tra các đơn vị hình thành khuẩn lạc (CFU - đơn vị dùng để định lượng vi sinh vật còn sống) có trong các đồ vật ở phòng tắm để xem đồ vật nào bẩn nhất. Kết quả đáng kinh ngạc khi không phải bồn cầu mà là rèm tắm, sàn tắm.
Trong khi đó, trung bình, phụ nữ chỉ vệ sinh phòng tắm 4 lần mỗi tháng, nam giới là 2,8 lần. Điều này khiến sàn tắm, rèm tắm là ổ chứa vi khuẩn với số lượng dồi dào không tưởng.
2. Bàn chải đánh răng

Bàn chải đánh răng có đến 12,6 triệu CFU. Nó thậm chí còn chứa nhiều vi khuẩn hơn cả tay nắm cửa bên trong nhà vệ sinh. Tốt nhất bạn nên để bàn chải đánh răng ra khu vực khác, ngoài phòng tắm và nhà vệ sinh.
3. Bồn cầu
Các chuyên gia sức khỏe cho biết, bồn cầu là ổ chứa vi khuẩn khổng lồ. Trong đó, 2 vật dụng chứa nhiều vi khuẩn nhất là nắp bồn cầu và cần gạt nước. Do đó, khi vệ sinh đừng bỏ qua 2 bộ phận quan trọng này ở toilet.
Theo Tuấn Minh (Phụ Nữ Việt Nam)
- Cầu thủ Argentina phải dùng thuốc an thần, hôn mê sau khi nhận tin mất vợ và 2 con vì thảm họa động đất Venezuela (13:44)
- C03 kêu gọi nhà đầu tư trong hệ sinh thái Shark Thủy bổ sung hồ sơ để bảo đảm quyền lợi (13:43)
- Dự báo điểm chuẩn tuyển sinh đại học năm 2026: Điểm chuẩn của nhiều trường đại học có thể giảm so với 2025? (13:43)
- Huỳnh Hiểu Minh bị chỉ trích ngầm hạ bệ vợ cũ sau phát ngôn gây tranh cãi tại concert Châu Kiệt Luân (13:39)
- "Siêu sedan" nhà Volkswagen chạy hybrid lộ khoang nội nhất ‘thương gia’: Xử đẹp’ Camry và Kia K5 (13:33)
- Phó Thủ tướng: Nghiên cứu sắp xếp 705 đơn vị hành chính cấp xã không đủ tiêu chuẩn trong năm 2026 (1 giờ trước)
- Cả nước có 5 thủ khoa đạt điểm tuyệt đối 30/30 kỳ thi tốt nghiệp THPT 2026 (2 giờ trước)
- Chỉ cần thêm một đĩa rau và đi bộ 15 phút mỗi ngày, sức khỏe có thể thay đổi đáng kể (2 giờ trước)
- Bất ngờ môn thi có nhiều điểm liệt nhất kỳ thi tốt nghiệp THPT 2026, vượt xa các môn còn lại (2 giờ trước)
- Hàn Quốc chính thức đón vị tân nữ Thủ tướng thứ hai trong lịch sử (2 giờ trước)